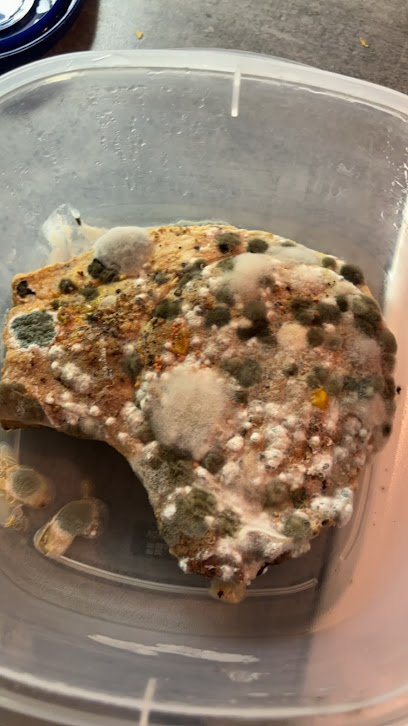
Background

Best Nightclubs near Le 658
Discover the best nightclubs near Le 658. Find inspiration for your trip with our curated list of top-rated spots, local favorites, and hidden gems.
- Home
- Canada
- Montreal
- Griffintown
- Le 658
- Best Nightclubs near Le 658
The 10 best nightclubs near Le 658
-
Time Supper Club
Dive into the exhilarating nightlife of Time Supper Club, Montreal's premier dance venue with vibrant music, delicious cocktails, and unforgettable experiences.
997 Rue Saint-Jacques door 1a, Montreal, Quebec H3C 1K13.9Good 219 Reviews -
Bar Le Confessionnal
Experience the vibrant nightlife at Bar Le Confessionnal in Montreal, where seductive ambiance meets eclectic drinks and dance.
431 McGill St, Montreal, Quebec H2Y 2H13.8Good 488 Reviews -
FRANCESCO'S DISCOTECA (Bar/Nightclub)
Unleash your night at Francesco's Discoteca, Montreal's top spot for dancing, cocktails, and an unforgettable nightlife experience.
394 Rue Saint-Jacques, Montréal, QC H2Y 1S14.5Excellent 119 Reviews -
Bord'Elle Boutique Bar & Eatery
Experience the vibrant culinary scene at Bord'Elle Boutique Bar & Eatery, where exquisite dining meets lively nightlife in the heart of Montreal.
390 Rue Saint-Jacques, Montréal, QC H2Y 1S14.2Very Good 2,163 Reviews -
La Voûte
La Voûte: Where Montreal's Historic Elegance Meets Unforgettable Nightlife Experiences in a Stunning Club Setting.
360 Rue Saint Jacques VS-201, Montréal, QC H2Y 1P54.0Very Good 915 Reviews -
Henden
Experience the vibrant nightlife of Montreal at Henden, where creative cocktails and a lively atmosphere await every visitor.
1800 Notre-Dame St W, Montreal, Quebec H3J 1M54.1Very Good 47 Reviews -
Bar Le Mal Nécessaire
Discover the vibrant atmosphere and exotic cocktails of Bar Le Mal Nécessaire, a must-visit cocktail bar in downtown Montreal.
1015 St Alexander St, Montreal, Quebec H2Z 1N94.5Excellent 1,729 Reviews -
212 Montréal
Discover the electrifying nightlife at 212 Montréal, where music, dance, and vibrant energy come together in the heart of the city.
212 Notre-Dame St W, Montreal, Quebec H2Y 1T33.7Good 182 Reviews -
Club 1234
Discover the electric nightlife at Club 1234 in Montreal, where vibrant beats and great company come together for an unforgettable evening.
1232 Rue de la Montagne, Montréal, QC H3G 1Z13.3Average 18 Reviews -
Upstairs Jazz Bar & Grill
Discover the perfect blend of live jazz and delectable grill cuisine at Upstairs Jazz Bar & Grill in the heart of Montreal.
1254 Mackay St, Montreal, Quebec H3G 2H44.6Excellent 1,816 Reviews
Other nightclubs near Le 658
-
Karina's Club Lounge
Discover the perfect blend of corporate entertainment and nightlife at Karina's Club Lounge in Montreal, where vibrant events come alive.
1455 Crescent St, Montreal, Quebec H3G 2B23.7Good 49 Reviews -
Velvet Speakeasy
Discover Velvet Speakeasy in Montreal: A vintage-inspired night club offering exquisite cocktails and a lively atmosphere for an unforgettable night out.
426 St Gabriel St, Montreal, Quebec H2Y 2Z93.8Good 124 Reviews -
ToutBon Bar & Night Club
ToutBon Bar & Night Club: Dive into Montreal's vibrant nightlife with electrifying music, dance, and a diverse crowd at this premier dance venue.
1469 Crescent St, Montreal, Quebec H3G 2B24.1Very Good 81 Reviews -
Club Electric Avenue
Discover the vibrant nightlife at Club Electric Avenue in Montreal, where energetic music and a diverse crowd create unforgettable nights.
1476 Crescent St, Montreal, Quebec H3G 2B63.4Average 247 Reviews -
Light Ultra Club
Discover the electric atmosphere of Light Ultra Club, Montreal's top night club for dancing, drinks, and unforgettable nightlife experiences.
2020 Crescent St, Montreal, Quebec H3G 2B83.4Average 13 Reviews -
Jet Night Club
Experience the vibrant nightlife at Jet Night Club in Montreal, where music and dance create unforgettable memories.
2020 Crescent St, Montreal, Quebec H3G 2B83.2Average 918 Reviews -
Afrotonik
Discover the pulsating nightlife at Afrotonik, Montreal's premier night club, where Afro music and vibrant energy create an unforgettable experience.
Arrondissement de Chartres, 1435 Rue de Bleury Bleury-Saint-Symphorien, Montréal, QC5.0Excellent 2 Reviews -
Vino Disco
Discover Vino Disco, a lively cocktail and wine bar in Montreal, where great music meets a vibrant atmosphere for an unforgettable night out.
1192 St Laurent Blvd, Montreal, Quebec H2X 2S64.6Excellent 74 Reviews -
Cabaret Fouf
Discover the electrifying nightlife of Cabaret Fouf, a vibrant night club in the heart of Montreal, famed for its captivating performances and inclusive atmosphere.
87 St Catherine St E, Montreal, Quebec H2X 1K54.3Very Good 3 Reviews -
Sunday Night Improv
Discover the vibrant comedy scene at Sunday Night Improv, Montreal's premier night club for spontaneous laughter and unforgettable performances.
264 St Catherine St E, Montreal, Quebec H2X 1L4 -
Newspeak
Discover the heart of Montreal's nightlife at Newspeak - a premier event venue blending music, art, and culture in a vibrant atmosphere.
1403 Rue Sainte-Elisabeth, Montréal, QC H2X 3C54.1Very Good 433 Reviews -
Montreal Skeleton Key
Dive into the electrifying nightlife at Montreal Skeleton Key, the ultimate disco club experience in the heart of Montreal's vibrant Plateau-Mont-Royal.
3435 St Laurent Blvd, Montreal, Quebec H2X 2T63.8Good 6 Reviews -
Palazo
Discover the vibrant nightlife at Palazo, Montreal's premier night club offering unforgettable experiences and eclectic music in a lively atmosphere.
3435 St Laurent Blvd, Montreal, Quebec H2X 2T64.7Excellent 1,184 Reviews -
Club École Privée
Discover the electrifying nightlife of Montreal at Club École Privée, where vibrant music and a dynamic crowd create unforgettable experiences.
3500 St Laurent Blvd, Montreal, Quebec H2X 2V23.0Average 297 Reviews -
Bistro à Jojo
Experience the best of Montreal's culinary delights and vibrant live performances at Bistro à Jojo, a cultural gem in the heart of the city.
1627 Saint Denis St, Montreal, Quebec H2X 3K34.4Very Good 1,206 Reviews -
Club Peopl
Dive into Montreal's nightlife at Club Peopl – a lively nightclub, bar, and event venue that promises unforgettable nights filled with music and dance.
3604 St Laurent Blvd, Montreal, Quebec H2X 2V43.5Good 495 Reviews -
PointBar Lounge
Experience the vibrant atmosphere of PointBar Lounge, a cocktail bar and club in Montreal, perfect for brunches and lively nightlife.
1735 Saint Denis St, Montreal, Quebec H2X 3K44.5Excellent 214 Reviews -
Stereo
Discover Stereo, Montreal's iconic night club renowned for its electrifying atmosphere, exceptional sound system, and unforgettable nightlife experience.
858 St Catherine St E, Montreal, Quebec H2L 2E34.1Very Good 802 Reviews -
Circus Afterhours
Dive into Montreal's nightlife at Circus Afterhours, where electrifying music and vibrant energy create unforgettable memories.
917 St Catherine St E, Montreal, Quebec H2L 3N53.5Good 195 Reviews -
Cabaret Mado
Discover the vibrant nightlife at Cabaret Mado, Montreal's premier cabaret club with dazzling performances and an unforgettable atmosphere.
1115 St Catherine St E, Montreal, Quebec H2L 2G24.4Very Good 1,075 Reviews -
Muzique
Experience the pulse of Montreal's nightlife at Muzique, where electrifying atmosphere meets diverse events and unforgettable nights.
3781 St Laurent Blvd, Montreal, Quebec H2W 1X83.6Good 1,279 Reviews -
Club Unity
Discover the energetic vibe of Club Unity in Montreal, where music, dancing, and unforgettable experiences come together in a lively atmosphere.
1171 St Catherine St E, Montreal, Quebec H2L 2G83.9Good 957 Reviews -
Complexe Sky
Discover Montreal's Complexe Sky, a vibrant gay nightclub offering delicious food, fabulous drinks, and unforgettable nights filled with dancing and entertainment.
1478 St Catherine St E, Montreal, Quebec H2L 2J13.6Good 1,017 Reviews -
BALATTOU
Discover the heartbeat of Montreal's nightlife at Balattou, a dynamic night club celebrated for its live music and vibrant atmosphere.
4372 St Laurent Blvd, Montreal, Quebec H2W 1Z54.4Very Good 279 Reviews -
Bar La Shop
Discover the lively nightlife of Montreal at Bar La Shop, where dancing, drinks, and unforgettable memories await.
4177 R. Saint-Denis 2e étage, Montréal, QC H2W 2M74.2Very Good 325 Reviews -
Cave Montreal - Venue
Dive into the heart of Montreal's nightlife at Cave Montreal, where electrifying music meets an unforgettable party atmosphere.
410 Rue Rachel E, Montréal, QC H2J 2G83.5Good 82 Reviews -
Le Belmont
Discover the vibrant nightlife of Montreal at Le Belmont, a dynamic nightclub offering diverse music and an electric atmosphere for an unforgettable experience.
4483 St Laurent Blvd, Montreal, Quebec H2W 1Z83.6Good 265 Reviews -
Rockette Bar
Discover the energetic nightlife of Rockette Bar in Montreal's Le Plateau-Mont-Royal, where music, fun, and culture collide.
4479 Saint Denis St, Montreal, Quebec H2J 2L24.2Very Good 666 Reviews -
Bar Datcha
Immerse yourself in Montreal's nightlife at Bar Datcha, where lively music and signature cocktails create an unforgettable experience.
98 Av. Laurier O, Montréal, QC H2T 2N44.2Very Good 473 Reviews
More about Le 658
Discover the lively charm and innovative cocktails at Le 658, a must-visit bar in the heart of Montreal's nightlife.
Tell me more about Le 658More to explore near Le 658
Get the latest from Evendo
Don't miss out on news and great deals












































